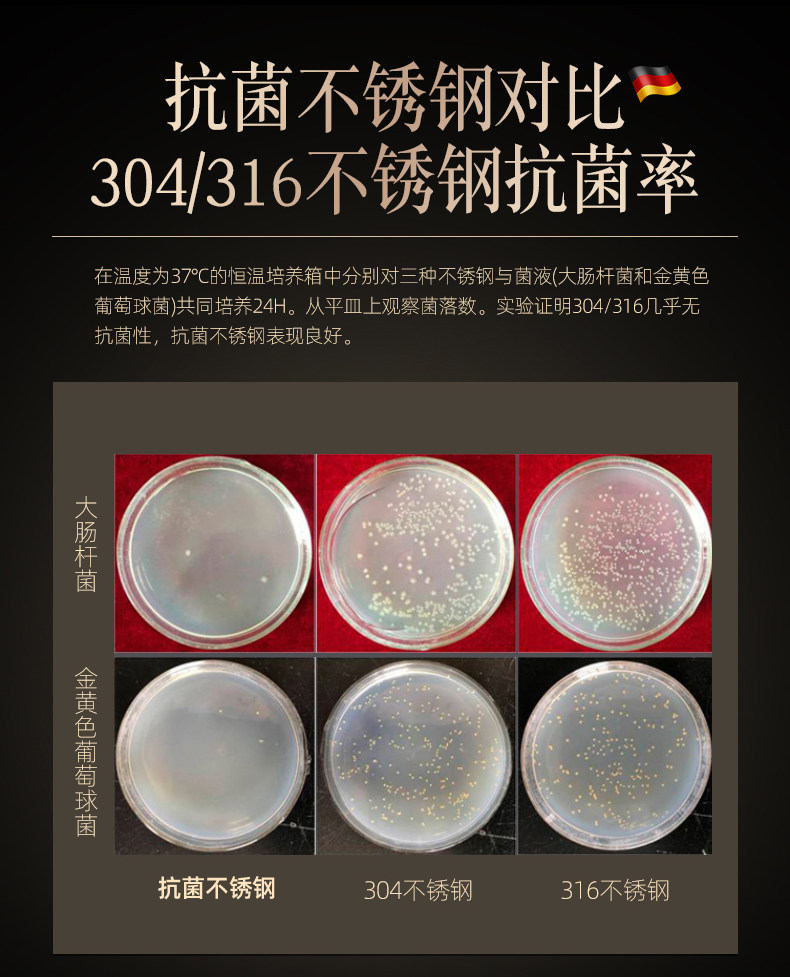

- Таобао
- Еда напиток инструмент
- Посуда
- Чашки
- 638404899143
Антибактериальная посуда из нержавеющей стали, комплект для домашнего использования для еды, Германия

Цена: 1 264-3 717руб. (¥59.8)
Артикул: 638404899143
Вес товара: ~0.7 кг. Указан усредненный вес, который может отличаться от фактического. Не включен в цену, оплачивается при получении.
Описание товараPGRpdj48aW1nIHNyYz0iaHR0cHM6Ly9pbWcuYWxpY2RuLmNvbS9pbWdleHRyYS9pMy8yOTg5NDQzMjA5L08xQ04wMWYyeDdIdjFaWmxkS1Q1UEZnXyEhMjk4OTQ0MzIwOS5qcGciPjwvZGl2PjxkaXY+PGltZyBzcmM9Imh0dHBzOi8vaW1nLmFsaWNkbi5jb20vaW1nZXh0cmEvaTQvMjk4OTQ0MzIwOS9PMUNOMDEzdFRDaTcxWlpsZEtUNWJpdl8hITI5ODk0NDMyMDkuanBnIj48L2Rpdj48ZGl2PjxpbWcgc3JjPSJodHRwczovL2ltZy5hbGljZG4uY29tL2ltZ2V4dHJhL2kxLzI5ODk0NDMyMDkvTzFDTjAxQ3dORjFmMVpabGdYemRXYTRfISEyOTg5NDQzMjA5LmpwZyI+PC9kaXY+PGRpdj48aW1nIHNyYz0iaHR0cHM6Ly9pbWcuYWxpY2RuLmNvbS9pbWdleHRyYS9pMi8yOTg5NDQzMjA5L08xQ04wMXNZclF4YTFaWmxnY3paNU1OXyEhMjk4OTQ0MzIwOS5qcGciPjwvZGl2PjxkaXY+PGltZyBzcmM9Imh0dHBzOi8vaW1nLmFsaWNkbi5jb20vaW1nZXh0cmEvaTMvMjk4OTQ0MzIwOS9PMUNOMDFUZFZ0VUwxWlpsZFFoa1dPMF8hITI5ODk0NDMyMDkuanBnIj48L2Rpdj48ZGl2PjxpbWcgc3JjPSJodHRwczovL2ltZy5hbGljZG4uY29tL2ltZ2V4dHJhL2kxLzI5ODk0NDMyMDkvTzFDTjAxb0d4bzdhMVpabGRLVDZrUFdfISEyOTg5NDQzMjA5LmpwZyI+PC9kaXY+PGRpdj48aW1nIHNyYz0iaHR0cHM6Ly9pbWcuYWxpY2RuLmNvbS9pbWdleHRyYS9pNC8yOTg5NDQzMjA5L08xQ04wMXo3enRFUjFaWmxkSGRlY0FqXyEhMjk4OTQ0MzIwOS5qcGciPjwvZGl2PjxkaXY+PGltZyBzcmM9Imh0dHBzOi8vaW1nLmFsaWNkbi5jb20vaW1nZXh0cmEvaTEvMjk4OTQ0MzIwOS9PMUNOMDE4bGlVd0MxWlpsZ1hRWlZoa18hITI5ODk0NDMyMDkuanBnIj48L2Rpdj48ZGl2PjxpbWcgc3JjPSJodHRwczovL2ltZy5hbGljZG4uY29tL2ltZ2V4dHJhL2k0LzI5ODk0NDMyMDkvTzFDTjAxMWtLTTIyMVpabGRIZGZRNW1fISEyOTg5NDQzMjA5LmpwZyI+PC9kaXY+PGRpdj48aW1nIHNyYz0iaHR0cHM6Ly9pbWcuYWxpY2RuLmNvbS9pbWdleHRyYS9pMy8yOTg5NDQzMjA5L08xQ04wMVNlb05EcTFaWmxnWE9idk5qXyEhMjk4OTQ0MzIwOS5qcGciPjwvZGl2PjxkaXY+PGltZyBzcmM9Imh0dHBzOi8vaW1nLmFsaWNkbi5jb20vaW1nZXh0cmEvaTQvMjk4OTQ0MzIwOS9PMUNOMDF2emZHWXMxWlpsZ1V1Tkt5Q18hITI5ODk0NDMyMDkuanBnIj48L2Rpdj48ZGl2PjxpbWcgc3JjPSJodHRwczovL2ltZy5hbGljZG4uY29tL2ltZ2V4dHJhL2kzLzI5ODk0NDMyMDkvTzFDTjAxYmlVVVJCMVpabGdQT1JvbWpfISEyOTg5NDQzMjA5LmpwZyI+PC9kaXY+PGRpdj48aW1nIHNyYz0iaHR0cHM6Ly9pbWcuYWxpY2RuLmNvbS9pbWdleHRyYS9pMy8yOTg5NDQzMjA5L08xQ04wMWNISjNHYTFaWmxnUHdKdjVDXyEhMjk4OTQ0MzIwOS5qcGciPjwvZGl2PjxkaXY+PGltZyBzcmM9Imh0dHBzOi8vaW1nLmFsaWNkbi5jb20vaW1nZXh0cmEvaTMvMjk4OTQ0MzIwOS9PMUNOMDFDanlvZGYxWlpsZE9mQ3F2bl8hITI5ODk0NDMyMDkuanBnIj48L2Rpdj48ZGl2PjxpbWcgc3JjPSJodHRwczovL2ltZy5hbGljZG4uY29tL2ltZ2V4dHJhL2kxLzI5ODk0NDMyMDkvTzFDTjAxV1V4R0Q2MVpabGdPUWJjUGtfISEyOTg5NDQzMjA5LmpwZyI+PC9kaXY+PGRpdj48aW1nIHNyYz0iaHR0cHM6Ly9pbWcuYWxpY2RuLmNvbS9pbWdleHRyYS9pMi8yOTg5NDQzMjA5L08xQ04wMVFnYUd0QTFaWmxkS1Q2RDlMXyEhMjk4OTQ0MzIwOS5qcGciPjwvZGl2PjxkaXY+PGltZyBzcmM9Imh0dHBzOi8vaW1nLmFsaWNkbi5jb20vaW1nZXh0cmEvaTMvMjk4OTQ0MzIwOS9PMUNOMDE2WERZemQxWlpsZEtESUFxU18hITI5ODk0NDMyMDkuanBnIj48L2Rpdj48ZGl2PjxpbWcgc3JjPSJodHRwczovL2ltZy5hbGljZG4uY29tL2ltZ2V4dHJhL2kyLzI5ODk0NDMyMDkvTzFDTjAxendmUzgzMVpabGRLVDZ3dTJfISEyOTg5NDQzMjA5LmpwZyI+PC9kaXY+PGRpdj48aW1nIHNyYz0iaHR0cHM6Ly9pbWcuYWxpY2RuLmNvbS9pbWdleHRyYS9pMi8yOTg5NDQzMjA5L08xQ04wMWZxa2lNVTFaWmxkQmVja09PXyEhMjk4OTQ0MzIwOS5qcGciPjwvZGl2PjxkaXY+PGltZyBzcmM9Imh0dHBzOi8vaW1nLmFsaWNkbi5jb20vaW1nZXh0cmEvaTIvMjk4OTQ0MzIwOS9PMUNOMDFwaGVWUFUxWlpsZFBJSjUxN18hITI5ODk0NDMyMDkuanBnIj48L2Rpdj48ZGl2PjxpbWcgc3JjPSJodHRwczovL2ltZy5hbGljZG4uY29tL2ltZ2V4dHJhL2kxLzI5ODk0NDMyMDkvTzFDTjAxb080eThrMVpabGRCZWdFZGhfISEyOTg5NDQzMjA5LmpwZyI+PC9kaXY+PGRpdj48aW1nIHNyYz0iaHR0cHM6Ly9pbWcuYWxpY2RuLmNvbS9pbWdleHRyYS9pMS8yOTg5NDQzMjA5L08xQ04wMUJmdVdkdjFaWmxkSzJLaUxTXyEhMjk4OTQ0MzIwOS5qcGciPjwvZGl2PjxkaXY+PGltZyBzcmM9Imh0dHBzOi8vaW1nLmFsaWNkbi5jb20vaW1nZXh0cmEvaTIvMjk4OTQ0MzIwOS9PMUNOMDFIcVJjTmgxWlpsZEtUNTRWOF8hITI5ODk0NDMyMDkuanBnIj48L2Rpdj48ZGl2PjxpbWcgc3JjPSJodHRwczovL2ltZy5hbGljZG4uY29tL2ltZ2V4dHJhL2kxLzI5ODk0NDMyMDkvTzFDTjAxMnJMWms2MVpabGRLVDc5T0xfISEyOTg5NDQzMjA5LmpwZyI+PC9kaXY+PGRpdj48aW1nIHNyYz0iaHR0cHM6Ly9pbWcuYWxpY2RuLmNvbS9pbWdleHRyYS9pMy8yOTg5NDQzMjA5L08xQ04wMVJyTVdsZTFaWmxkTEJGRFdSXyEhMjk4OTQ0MzIwOS5qcGciPjwvZGl2PjxkaXY+PGltZyBzcmM9Imh0dHBzOi8vaW1nLmFsaWNkbi5jb20vaW1nZXh0cmEvaTMvMjk4OTQ0MzIwOS9PMUNOMDFuM2VxcUQxWlpsZEtER0E5SF8hITI5ODk0NDMyMDkuanBnIj48L2Rpdj48ZGl2PjxpbWcgc3JjPSJodHRwczovL2ltZy5hbGljZG4uY29tL2ltZ2V4dHJhL2kzLzI5ODk0NDMyMDkvTzFDTjAxZWVRVjhaMVpabGRLVDdMcnlfISEyOTg5NDQzMjA5LmpwZyI+PC9kaXY+PGRpdj48aW1nIHNyYz0iaHR0cHM6Ly9pbWcuYWxpY2RuLmNvbS9pbWdleHRyYS9pMy8yOTg5NDQzMjA5L08xQ04wMVJJQ2M0TzFaWmxkSUZaalBZXyEhMjk4OTQ0MzIwOS5qcGciPjwvZGl2PjxkaXY+PGltZyBzcmM9Imh0dHBzOi8vaW1nLmFsaWNkbi5jb20vaW1nZXh0cmEvaTEvMjk4OTQ0MzIwOS9PMUNOMDFaU3pJcnoxWlpsZFFoaUpBbV8hITI5ODk0NDMyMDkuanBnIj48L2Rpdj48ZGl2PjxpbWcgc3JjPSJodHRwczovL2ltZy5hbGljZG4uY29tL2ltZ2V4dHJhL2kzLzI5ODk0NDMyMDkvTzFDTjAxbmlYemx2MVpabGRLVDRmWVVfISEyOTg5NDQzMjA5LmpwZyI+PC9kaXY+PGRpdj48aW1nIHNyYz0iaHR0cHM6Ly9pbWcuYWxpY2RuLmNvbS9pbWdleHRyYS9pNC8yOTg5NDQzMjA5L08xQ04wMXhXOGdJSjFaWmxnWXZMbkJ3XyEhMjk4OTQ0MzIwOS5qcGciPjwvZGl2PjxkaXY+PGltZyBzcmM9Imh0dHBzOi8vaW1nLmFsaWNkbi5jb20vaW1nZXh0cmEvaTQvMjk4OTQ0MzIwOS9PMUNOMDE2VDJSSEYxWlpsZE1ERG1tZF8hITI5ODk0NDMyMDkuanBnIj48L2Rpdj48ZGl2PjxpbWcgc3JjPSJodHRwczovL2ltZy5hbGljZG4uY29tL2ltZ2V4dHJhL2kxLzI5ODk0NDMyMDkvTzFDTjAxeTJIbHduMVpabGRPZkRTT2xfISEyOTg5NDQzMjA5LmpwZyI+PC9kaXY+PGRpdj48aW1nIHNyYz0iaHR0cHM6Ly9pbWcuYWxpY2RuLmNvbS9pbWdleHRyYS9pNC8yOTg5NDQzMjA5L08xQ04wMU9sSTRTUzFaWmxkUWhoQVVYXyEhMjk4OTQ0MzIwOS5qcGciPjwvZGl2PjxkaXY+PGltZyBzcmM9Imh0dHBzOi8vaW1nLmFsaWNkbi5jb20vaW1nZXh0cmEvaTQvMjk4OTQ0MzIwOS9PMUNOMDFvYVdDcjYxWlpsZE9mRVd0dV8hITI5ODk0NDMyMDkuanBnIj48L2Rpdj48ZGl2PjxpbWcgc3JjPSJodHRwczovL2ltZy5hbGljZG4uY29tL2ltZ2V4dHJhL2k0LzI5ODk0NDMyMDkvTzFDTjAxUldwYklTMVpabGRIZGdoOEVfISEyOTg5NDQzMjA5LmpwZyI+PC9kaXY+PGRpdj48aW1nIHNyYz0iaHR0cHM6Ly9pbWcuYWxpY2RuLmNvbS9pbWdleHRyYS9pMi8yOTg5NDQzMjA5L08xQ04wMUpaUHVBTDFaWmxkTFJMbUo4XyEhMjk4OTQ0MzIwOS5qcGciPjwvZGl2PjxkaXY+PGltZyBzcmM9Imh0dHBzOi8vaW1nLmFsaWNkbi5jb20vaW1nZXh0cmEvaTIvMjk4OTQ0MzIwOS9PMUNOMDFBaUNZQTYxWlpsZExSTGk4b18hITI5ODk0NDMyMDkuanBnIj48L2Rpdj48ZGl2PjxpbWcgc3JjPSJodHRwczovL2ltZy5hbGljZG4uY29tL2ltZ2V4dHJhL2k0LzI5ODk0NDMyMDkvTzFDTjAxY0FqdzhmMVpabGROSDZKdWJfISEyOTg5NDQzMjA5LmpwZyI+PC9kaXY+PGRpdj48aW1nIHNyYz0iaHR0cHM6Ly9pbWcuYWxpY2RuLmNvbS9pbWdleHRyYS9pNC8yOTg5NDQzMjA5L08xQ04wMTMzWDZJRDFaWmxkUUFiT3R1XyEhMjk4OTQ0MzIwOS5qcGciPjwvZGl2PjxkaXY+PGltZyBzcmM9Imh0dHBzOi8vaW1nLmFsaWNkbi5jb20vaW1nZXh0cmEvaTMvMjk4OTQ0MzIwOS9PMUNOMDFoM0hBQU4xWlpsZE9mRjhLT18hITI5ODk0NDMyMDkuanBnIj48L2Rpdj48ZGl2PjxpbWcgc3JjPSJodHRwczovL2ltZy5hbGljZG4uY29tL2ltZ2V4dHJhL2kzLzI5ODk0NDMyMDkvTzFDTjAxR0I2bGpvMVpabGRLVDdZTUFfISEyOTg5NDQzMjA5LmpwZyI+PC9kaXY+PGRpdj48aW1nIHNyYz0iaHR0cHM6Ly9pbWcuYWxpY2RuLmNvbS9pbWdleHRyYS9pMi8yOTg5NDQzMjA5L08xQ04wMVIwcFVGQTFaWmxkTkg4ZlNxXyEhMjk4OTQ0MzIwOS5qcGciPjwvZGl2PjxkaXY+PGltZyBzcmM9Imh0dHBzOi8vaW1nLmFsaWNkbi5jb20vaW1nZXh0cmEvaTMvMjk4OTQ0MzIwOS9PMUNOMDFTaXNlYVAxWlpsZEtERjFTRV8hITI5ODk0NDMyMDkuanBnIj48L2Rpdj48ZGl2PjxpbWcgc3JjPSJodHRwczovL2ltZy5hbGljZG4uY29tL2ltZ2V4dHJhL2kyLzI5ODk0NDMyMDkvTzFDTjAxNlNLa3JnMVpabGROSDhTemNfISEyOTg5NDQzMjA5LmpwZyI+PC9kaXY+PGRpdj48aW1nIHNyYz0iaHR0cHM6Ly9pbWcuYWxpY2RuLmNvbS9pbWdleHRyYS9pMy8yOTg5NDQzMjA5L08xQ04wMUdhaDBIWjFaWmxkUElJa0ZVXyEhMjk4OTQ0MzIwOS5qcGciPjwvZGl2PjxkaXY+PGltZyBzcmM9Imh0dHBzOi8vaW1nLmFsaWNkbi5jb20vaW1nZXh0cmEvaTEvMjk4OTQ0MzIwOS9PMUNOMDFtNDJyWm4xWlpsZEtUNGZhNF8hITI5ODk0NDMyMDkuanBnIj48L2Rpdj48ZGl2PjxpbWcgc3JjPSJodHRwczovL2ltZy5hbGljZG4uY29tL2ltZ2V4dHJhL2kxLzI5ODk0NDMyMDkvTzFDTjAxRk52SWNTMVpabGdaRHZVNzFfISEyOTg5NDQzMjA5LmpwZyI+PC9kaXY+PGRpdj48aW1nIHNyYz0iaHR0cHM6Ly9pbWcuYWxpY2RuLmNvbS9pbWdleHRyYS9pMi8yOTg5NDQzMjA5L08xQ04wMVN0cVhKeDFaWmxkSzJMSm84XyEhMjk4OTQ0MzIwOS5qcGciPjwvZGl2PjxkaXY+PGltZyBzcmM9Imh0dHBzOi8vaW1nLmFsaWNkbi5jb20vaW1nZXh0cmEvaTMvMjk4OTQ0MzIwOS9PMUNOMDE3ZjkzM1gxWlpsZ1h6Y3IwSF8hITI5ODk0NDMyMDkuanBnIj48L2Rpdj48ZGl2PjxpbWcgc3JjPSJodHRwczovL2ltZy5hbGljZG4uY29tL2ltZ2V4dHJhL2kyLzI5ODk0NDMyMDkvTzFDTjAxdXhwdTZrMVpabGROSDkwR0VfISEyOTg5NDQzMjA5LmpwZyI+PC9kaXY+PGRpdj48aW1nIHNyYz0iaHR0cHM6Ly9pbWcuYWxpY2RuLmNvbS9pbWdleHRyYS9pMy8yOTg5NDQzMjA5L08xQ04wMUtKZERMejFaWmxkT2ZFS1N1XyEhMjk4OTQ0MzIwOS5qcGciPjwvZGl2PjxkaXY+PGltZyBzcmM9Imh0dHBzOi8vaW1nLmFsaWNkbi5jb20vaW1nZXh0cmEvaTMvMjk4OTQ0MzIwOS9PMUNOMDFtdnlBaVgxWlpsZFFoanpCcV8hITI5ODk0NDMyMDkuanBnIj48L2Rpdj48ZGl2PjxpbWcgc3JjPSJodHRwczovL2ltZy5hbGljZG4uY29tL2ltZ2V4dHJhL2kzLzI5ODk0NDMyMDkvTzFDTjAxSnZjTWVBMVpabGRCZWQ5T1RfISEyOTg5NDQzMjA5LmpwZyI+PC9kaXY+PGRpdj48aW1nIHNyYz0iaHR0cHM6Ly9pbWcuYWxpY2RuLmNvbS9pbWdleHRyYS9pNC8yOTg5NDQzMjA5L08xQ04wMVBTazBMazFaWmxkTkg5b0E4XyEhMjk4OTQ0MzIwOS5qcGciPjwvZGl2PjxkaXY+PGltZyBzcmM9Imh0dHBzOi8vaW1nLmFsaWNkbi5jb20vaW1nZXh0cmEvaTMvMjk4OTQ0MzIwOS9PMUNOMDE1a2ZOZGoxWlpsZExCRmNWZV8hITI5ODk0NDMyMDkuanBnIj48L2Rpdj4=
Продавец:kunzhan旗舰店
Рейтинг:

Всего отзывов:0
Положительных:0
Выберите вариацию / цвет
Добавить в корзину
- Информация о товаре
- Фотографии
| Цвет: | Из нержавеющей стали, антибактериальный, диаметр 12мм, 12см, Из нержавеющей стали, антибактериальный, диаметр 13мм, 13см, Антибактериальные детские палочки для еды из нержавеющей стали, ложка, 1 шт, 1 шт, Антибактериальная чаша из нержавеющей стали - 1 миска для взрослых + 1 двойные шлюпсы для взрослых + 1 ложка, Антибактериальные детские палочки для еды из нержавеющей стали, ложка, 2 шт, 2 шт, Антибактериальная чаша из нержавеющей стали-2 чаша для взрослых+2 двойных шлюпска для взрослых+2 ложки, Антибактериальные детские палочки для еды из нержавеющей стали, ложка, 4 шт, 4 шт, Антибактериальная чаша из нержавеющей стали-4 чаша для взрослых+4 двойных палочки для взрослых+4 ложки |